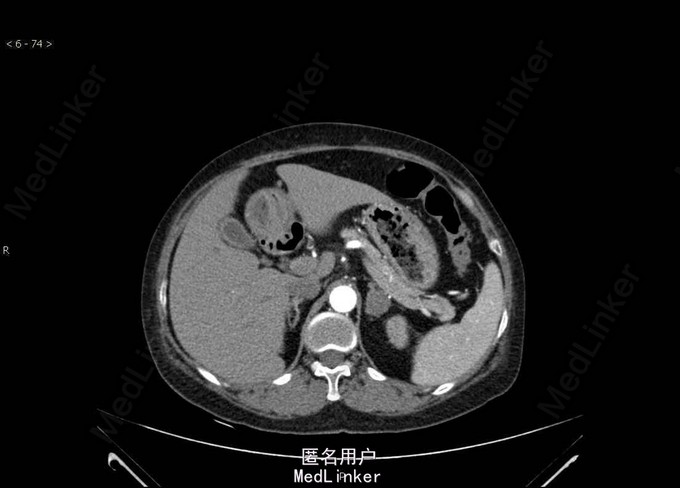

下载或打开 医联APP 查看完整评论
立即下载
打开APP
发现高血压8年 患者于8年前出现头晕,当时监测血压诊断“高血压”“长期服用降压药,血压波动明显,最高血压波动在170-180/80-110mmHg,1月前出现头痛伴视物障碍就诊我院,今为求进一步诊治就诊我科。
Bp:168/112mmHg,其余无特殊。 肾上腺CT:左侧肾上腺结节,考虑腺瘤可能性大。双肾、脾脏多发囊肿。双肾动脉CTA检查未见明确病变。左侧肾上腺见一大小约25mm×22mm的结节影,CT值约40HU,增强扫描可见强化。右侧肾上腺大小、形态及密度未见明确异常。 术后病理示肾上腺皮质腺瘤。

诊断:左侧肾上腺皮质腺瘤 在全麻下行“肾上腺切除术,经腹腹腔镜,术程顺利,术后恢复好。
讨论:发生在肾上腺皮质球状带并能分泌醛固酮的良性腺瘤,称醛固酮瘤。是原发性醛固酮增多症中最常见的一种,约占原醛症的65%,以肾上腺单个肿瘤多见。醛固酮瘤患者的临床表现和生化特征较其他各型原醛症更典型。